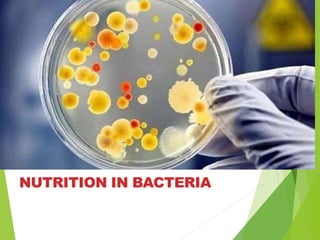
NUTRITION IN BACTERIA
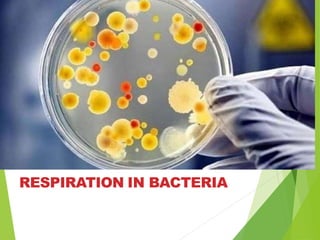
RESPIRATION IN BACTERIA

This document discusses bacteria at the kingdom level. It describes their key characteristics including their prokaryotic cell structure, size, shape, cell components, and methods of nutrition and growth. It also covers the important discoveries of van Leewenhoek, Pasteur, and Koch in microbiology. The document discusses the ecological, economic, and medical importance of bacteria and various methods used to control bacteria.